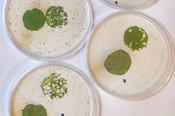

Fraßfeind im Haus
Im Mädchen-Projekt „NATürlich“ an der Freien Universität lernen Schülerinnen die Arbeit von Naturwissenschaftlerinnen kennen – derzeit läuft die Seminarreihe virtuell: mit Experimenten für zu Hause
15.01.2021
Paula Leupold ist studentische Mitarbeiterin im NatLab, dem Mitmach- und Experimentierlabor für Schülerinnen und Schüler am Fachbereich Biologie, Chemie, Pharmazie der Freien Universität Berlin. Dort betreut die Biochemiestudentin das Projekt „NATürlich – Mädchen treffen Naturwissenschaftlerinnen“. Für diese kostenfreie Seminarreihe können sich Schülerinnen ab der 10. Klasse anmelden. Gemeinsam treffen sie Wissenschaftlerinnen der Chemie, Biologie und Pharmazie coronabedingt online, hören Vorträge zu deren Forschungsthemen, diskutieren und experimentieren nach Anleitung zu Hause.
Per Videokonferenz lernten die Teilnehmerinnen des Mädchen-Projekts „NATürlich“ die Arbeit der Biologin Vivian Lortzing kennen.
Bildquelle: Paula Leupold
„Bei NATürlich geht es darum, dass Mädchen weibliche Vorbilder aus den Naturwissenschaften kennenlernen und Einblicke in Berufswege bekommen“, sagt Paula Leupold. Deshalb erhielten die Teilnehmerinnen vor jedem Treffen einen ausführlichen Lebenslauf der gastgebenden Wissenschaftlerin.
Als Schülerin habe sie vor einigen Jahren selbst an dem Programm teilgenommen und sich aufgrund dieser Erfahrung für das Studium der Biochemie entschieden. Damals haben Paula Leupold vor allem die Laborbesuche und die praktischen Experimente fasziniert. „Deswegen fand ich es so schade, dass das Programm im Moment aufgrund der Corona-Pandemie nur über Videokonferenzen stattfinden kann“, sagt sie.
Statt auf dem Campus experimentieren die Mädchen jetzt als Vorbereitung auf die virtuellen Treffen zu Hause. Für den Termin mit der promovierten Biologin Vivien Lortzing kamen die Materialien dafür sogar per Post ins Haus.
Durch Experimente werden Naturwissenschaften erst spannend, findet die Biologin Vivien Lortzing. Deshalb hat sie vor ihrem NATürlich-Seminar Pakete gepackt.
Bildquelle: Vivien Lortzing
Chinakohl per Post
Vivien Lortzing erforscht, wie Pflanzen sich gegen Herbivoren, also pflanzenfressende Insekten, verteidigen. Ihre Arbeit ist Teil des Sonderforschungsbereichs 973, in dem Wissenschaftlerinnen und Wissenschaftler verschiedener Disziplinen gemeinsam untersuchen, wie Pflanzen, Pilze und Bakterien sich an Stressfaktoren wie Wärme, Kälte oder Insektenfraß „erinnern“ und auf diese Weise Stressfolgen rechtzeitig abwehren oder mildern können.
Bereits einige Wochen vor dem virtuellen NATürlich-Treffen hat die Biologin Pakete gepackt und an die Schülerinnen verschickt. Jedes Paket enthielt eine Chinakohl-Pflanze mit Wurzelballen, einige lebende Meerettichblattkäfer, ein Gefäß mit Tabakkrümeln, Petrischalen, Pipetten und eine Anleitung für ein Experiment. Die Forschungsfrage lautete: Wie wirkt sich die Behandlung eines Blattes mit Nikotin auf das Fraßverhalten der Käfer aus?
„Es war toll, mit Gegenständen zu arbeiten, die auch in echten Forschungslaboren verwendet werden“, sagt die Schülerin Aala, als das Online-Treffen mit Paula Leupold und Vivien Lortzing schließlich stattfindet.
Chinakohl-Pflanzen, Käfer, Petrischalen, Pipetten und eine Anleitung für das Experiment kamen per Post zu den Teilnehmerinnen.
Bildquelle: Vivien Lortzing
Weitere Teilnehmerinnen berichten, dass ihre Familienmitglieder zwar anfangs Vorbehalte gegen Käfer im Haus gehabt hätten, sie aber schließlich das Experiment doch durchführen konnten: Blattteile ausstanzen, die Hälfte der Blattteile in eine Tabak-Wasser-Mischung einlegen, dann ein normales und ein Nikotin-getränktes Blatt zusammen mit einem Käfer in eine Petrischale geben, abwarten, beobachten, fotografieren.
Leoni berichtet, dass sie vor dem Versuch zwei Hypothesen hatte: „Entweder der Käfer frisst das Nikotinblatt nicht, oder er frisst es und stirbt.“ Wie die anderen Schülerinnen auch, konnte sie dann beobachten, dass das Nikotinblatt verschmäht wurde. Sind Meerrettichblattkäfer also schlauer als Menschen, die wider besseres Wissen Tabak rauchen? „Sieht so aus“, sagt Vivien Lortzing. Nikotin sei ein hochwirksames Gift, das Tabakpflanzen produzieren, um Fraßfeinde abzuschrecken. Es tue Insekten nicht gut – und Menschen auch nicht.
Nikotin im Blut hilft gegen Spinnen
Amelie hat den Versuch auf eigene Faust um ein paar Tage verlängert. Sie wollte sehen, ob der Käfer das Nikotinblatt vielleicht doch noch frisst, wenn das andere Blatt aufgegessen ist. „Hat er aber nicht“, berichtet sie. „Schlaues Tier!“
Das Gift helfe der Tabakpflanze jedoch nicht gegen alle Feinde, erläutert Vivien Lortzing: „Die Raupe des Tabakschwärmers hat eine Gegenstrategie entwickelt: Sie nimmt das Nikotin über die Nahrung ins Blut auf und gibt es über Öffnungen der Haut wieder an die Umgebung ab. Sie stinkt und schreckt damit wiederum ihre eigenen Fraßfeinde, nämlich Spinnen, ab.“
Über viele weitere Fachfragen wird anschließend diskutiert: Ist Kulturtabak, der weniger Nikotin enthält, anfälliger für Fraß? Kann man wilden Tabak vielleicht als Insektizid einsetzen?
Schließlich kommen die Schülerinnen auch auf den beruflichen Werdegang der Wissenschaftlerin zu sprechen: Warum sie sich gerade dieses Forschungsthema ausgesucht habe, möchte eine Teilnehmerin wissen. „Auf diesem Gebiet kann ich alles kombinieren, was mich interessiert: Biochemie, Ökologie und Genetik, Labor- und Feldarbeit“, sagt Vivien Lortzing. „Außerdem ist es ein tolles Gefühl, wenn man einen Mechanismus entdeckt, der bisher noch unbekannt war.“
So habe sie etwa kürzlich herausgefunden, dass Pflanzen sogar „ökonomisch handeln“: Wenn sie bereits Samen – also Nachkommen – produziert haben, verteidigen sie sich nicht mehr gegen Fraßfeinde, vermutlich deshalb, weil ihr Fortbestehen dann bereits gesichert ist.
Vorurteile abbauen
Eine Teilnehmerin nutzt die Gelegenheit für eine persönliche Frage: Weil sie sich für Biologie interessiere und Vegetarierin sei, werde sie häufig als „Öko-Fuzzi“ abgestempelt. Ob es der Wissenschaftlerin auch so ginge, wollte sie gern wissen.
„Ja, solche Vorurteile kenne ich“, sagt Vivien Lortzing. „Wenn ich mich als Ökologin vorstelle, wundern sich alle, dass ich nicht in Graubraun gekleidet, sondern modisch angezogen und geschminkt bin.“ Wenn sie sich jedoch als Genetikerin vorstelle, dann werde sie gleich mit Vorbehalten zur „bösen Gentechnologie“ konfrontiert. „Aber deswegen gibt es ja solche Programme wie NATürlich – auch, um Vorurteile abzubauen.“
Weitere Informationen
Der nächste Durchgang der kostenfreien Seminarreihe „NATürlich“ beginnt am 11. Februar und endet am 27. Mai 2021. Die Online-Veranstaltungen finden jeweils donnerstags von 17 bis 19 Uhr statt. Die Anmeldung ist ab sofort möglich unter: https://www.buchsys.de/fu-natlab/angebote/aktueller_zeitraum/_NATuerlich.html